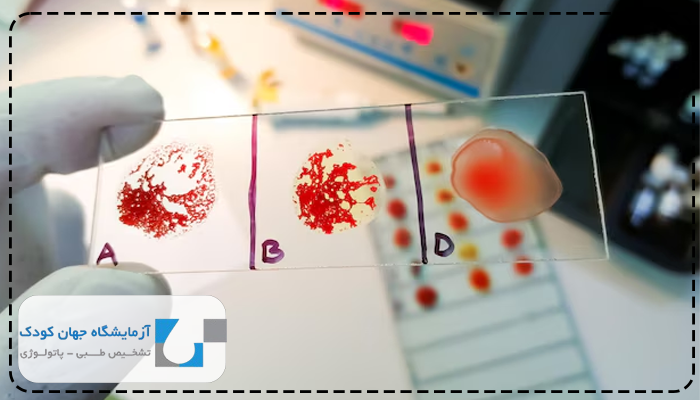
آزمایش لام خون محیطی برای چیست

آزمایش لام خون محیطی یکی از مهمترین روشهای بررسی وضعیت سلولهای خونی است که اطلاعات بسیار دقیقی درباره سلامت عمومی بدن در اختیار پزشک قرار میدهد. آزمایش لام خون محیطی از طریق مشاهده مستقیم سلولهای خونی زیر میکروسکوپ انجام میشود و به کمک آن میتوان اختلالات مختلفی مانند کمخونی، عفونت، التهاب یا بیماریهای مغز استخوان را شناسایی کرد. در این مقاله بهصورت کامل و ساده توضیح داده میشود که آزمایش لام خون محیطی چیست، در چه شرایطی پزشک آن را تجویز میکند، مراحل انجام آن چگونه است و نتایج آن چه مفهومی دارد.
آزمایش لام خون محیطی چیست و چه کاربردی دارد؟
آزمایش لام خون محیطی روشی است که در آن نمونهای از خون روی لام شیشهای پخش و رنگآمیزی میشود تا سلولهای آن زیر میکروسکوپ بررسی شوند. این آزمایش کاربردهای گستردهای در تشخیص بیماریهای خونی دارد. آزمایش لام خون محیطی به پزشک کمک میکند تا تعداد، اندازه، شکل و وضعیت سلولهای خونی گلبولهای قرمز، سفید و پلاکتها را ببیند. مشاهده مستقیم سلولها به تشخیص بیماریهایی کمک میکند که ممکن است در آزمایشهای خودکار مانند CBC بهطور کامل مشخص نشوند.
لام خون محیطی شامل چه نوع سلولهایی است؟
لام خون محیطی شامل سه نوع سلول اصلی است که هرکدام وظیفهای خاص در بدن دارند:
- گلبولهای قرمز (RBC): این سلولها اکسیژن را از ریهها به بافتها میرسانند. تغییر در اندازه یا شکل آنها میتواند نشانه کمخونی یا بیماریهای ژنتیکی باشد.
- گلبولهای سفید (WBC): سلولهایی که در دفاع بدن در برابر عفونتها نقش دارند. افزایش یا کاهش تعداد آنها میتواند علامت عفونت، التهاب یا سرطانهای خونی باشد.
- پلاکتها (Platelets): ذرات کوچکی که در لخته شدن خون موثرند. کاهش پلاکت میتواند خطر خونریزی را افزایش دهد.
برای دریافت نوبت و مشاوره از آزمایشگاه جهان کودک بر روی دکمههای زیر کلیک کنید. این مرکز با دستگاه های مدرن و تکنولوژی پیشرفته آماده انجام کلیه تست های بالینی و آسیب شناسی می باشد و آزمایشات توسط تکنسین های با تجربه و با دستگاههای تمام اتوماتیک انجام میشود که در آن خطای انسانی به حداقل میرسد.
در چه شرایطی پزشک آزمایش لام خون محیطی را تجویز میکند؟
آزمایش لام خون محیطی زمانی تجویز میشود که نتایج آزمایش CBC غیرعادی باشد یا علائمی از اختلالات خونی در بیمار مشاهده شود. پزشک از این آزمایش برای بررسی دقیقتر سلولها و تشخیص علت تغییرات استفاده میکند.
بیشتر بخوانید: آزمایش پیروات
لام خون محیطی در تشخیص چه بیماریهایی کاربرد دارد؟
لام خون محیطی در تشخیص طیف وسیعی از بیماریها به کار میرود، از جمله:
- کمخونیهای مختلف (فقر آهن، همولیتیک، مگالوبلاستیک)
- عفونتهای باکتریایی و ویروسی
- لوسمی (سرطان خون)
- مالاریا و سایر انگلهای خونی
- اختلالات پلاکتی و خونریزیهای غیرطبیعی
هرکدام از این موارد با تغییر در شکل یا تعداد سلولها قابل شناسایی است.
مراحل انجام آزمایش لام خون محیطی چگونه است؟
آزمایش لام خون محیطی مراحل دقیقی دارد که رعایت هر مرحله برای دقت نتیجه اهمیت بالایی دارد. ابتدا نمونه خون گرفته میشود که از ورید بازو مقدار کمی خون به دست میآید. این نمونه سپس روی لام شیشهای قرار میگیرد و بهصورت لایهای نازک پخش میشود تا امکان مشاهده دقیق سلولها فراهم شود.
پس از تهیه لام، مرحله رنگآمیزی آغاز میشود. در این مرحله از رنگهای مخصوص مانند رنگ رایت (Wright) استفاده میشود تا سلولها به وضوح دیده شوند و تمایز بین انواع سلولها آسانتر شود. در نهایت، لام زیر میکروسکوپ بررسی میشود و پزشک آزمایشگاه سلولها را از نظر اندازه، شکل، ترکیب و سایر ویژگیها ارزیابی میکند تا هرگونه تغییر غیرطبیعی شناسایی شود.
در بررسی میکروسکوپی لام خون به چه نکاتی توجه میشود؟
در بررسی میکروسکوپی لام خون، توجه به چند نکته بسیار مهم است:
- یکنواخت بودن پخش خون روی لام
- عدم وجود حباب یا لخته
- تمیز بودن زمینه لام
- رنگآمیزی مناسب برای تشخیص دقیق سلولها
هرگونه خطا در این مراحل میتواند باعث تفسیر نادرست نتیجه شود.
نتایج آزمایش لام خون محیطی چه اطلاعاتی درباره سلامت فرد میدهد؟
نتایج آزمایش لام خون محیطی اطلاعات کاملی درباره وضعیت سیستم خونی فرد ارائه میدهد. پزشک با مشاهده تغییرات ظاهری سلولها میتواند وجود بیماریهای مختلف را حدس بزند.
نتایج غیرطبیعی در لام خون محیطی چه معنا دارد؟
نتایج غیرطبیعی ممکن است نشاندهنده شرایط زیر باشد:
- تغییر شکل گلبولهای قرمز → کمخونی فقر آهن یا تالاسمی
- افزایش گلبولهای سفید → عفونت یا التهاب
- وجود سلولهای نارس → مشکلات مغز استخوان
- کاهش پلاکتها → احتمال خونریزی
این موارد باید همیشه همراه با سایر آزمایشها و علائم بالینی تفسیر شوند.

بیشتر بخوانید: آزمایش لاکتات
تفاوت آزمایش لام خون محیطی با سایر آزمایشهای خون چیست؟
آزمایش لام خون محیطی با سایر آزمایشهای خون تفاوت مهمی دارد زیرا در این روش سلولها مستقیما زیر میکروسکوپ دیده میشوند. در حالیکه آزمایشهای خودکار مانند CBC تنها به شمارش سلولها بسنده میکنند.
چه تفاوتی بین اسمیر خون محیطی و CBC وجود دارد؟
اسمیر خون محیطی با CBC از نظر روش و نوع اطلاعات متفاوت است:
| ویژگی | لام خون محیطی | CBC |
|---|---|---|
| روش انجام | مشاهده سلولها زیر میکروسکوپ | شمارش خودکار سلولها |
| نوع اطلاعات | شکل، اندازه و ساختار سلولها | تعداد و درصد سلولها |
| کاربرد | تشخیص دقیق نوع اختلال خونی | بررسی اولیه وضعیت خونی |
| نیاز به تفسیر انسانی | دارد | ندارد |
آیا انجام آزمایش لام خون محیطی نیاز به آمادگی خاصی دارد؟
آزمایش لام خون محیطی نیاز به آمادگی خاصی ندارد. با این حال، اگر بیمار داروی خاصی مصرف میکند باید پزشک را مطلع کند، زیرا برخی داروها ممکن است بر نتایج تاثیر بگذارند.
آیا این آزمایش برای همه بیماران ضروری است؟
آزمایش لام خون محیطی برای همه افراد الزامی نیست. تنها زمانی انجام میشود که پزشک بر اساس علائم یا نتایج CBC به وجود مشکل مشکوک شود. مثلاً در موارد کمخونی، تب طولانی، کبودی بیدلیل یا ضعف عمومی.
تفسیر نتایج لام خون محیطی چگونه انجام میشود؟
تفسیر نتایج لام خون محیطی به تجربه متخصص آزمایشگاه بستگی دارد. او با مشاهده شکل، رنگ و نسبت سلولها میتواند نوع بیماری را تشخیص دهد.
چگونه میتوان از بروز خطا در تهیه لام خون جلوگیری کرد؟
برای جلوگیری از خطا در تهیه لام خون باید:
- از لام تمیز و خشک استفاده شود
- قطره خون نه زیاد باشد نه کم
- پخش لام در زاویه مناسب انجام شود
- لام بلافاصله خشک و سپس رنگآمیزی شود
رعایت این موارد باعث افزایش دقت در نتایج میشود.

بیشتر بخوانید: آزمایش آمیلاز
چه عواملی میتوانند بر دقت آزمایش لام خون محیطی تاثیر بگذارند؟
دقت آزمایش لام خون محیطی به عوامل متعددی بستگی دارد که هر یک میتوانند نتایج را تحت تاثیر قرار دهند. یکی از مهمترین عوامل، کیفیت نمونه خون است. اگر نمونه خون دارای لخته باشد یا بین زمان گرفتن نمونه و تهیه لام تأخیر زیادی وجود داشته باشد، شکل سلولها تغییر میکند و بررسی دقیق آنها دشوار میشود. به همین دلیل نمونه باید تازه و بدون لخته تهیه شود.
عامل دیگر، مهارت فردی است که لام را تهیه میکند. پخش کردن خون روی لام، خشک کردن صحیح و رنگآمیزی مناسب نیاز به تجربه دارد. اگر این مراحل بهدرستی انجام نشوند، سلولها به شکل صحیح قابل مشاهده نیستند و نتیجه آزمایش ممکن است اشتباه تفسیر شود.
همچنین نوع رنگآمیزی و کیفیت مواد شیمیایی مورد استفاده نقش مهمی دارد. رنگهای مخصوص لام باید تازه و مطابق استاندارد باشند تا سلولها به خوبی مشخص شوند. در غیر این صورت برخی جزئیات سلولی ممکن است مخفی بماند و تشخیص دقیق دشوار شود.
در نهایت، شرایط نگهداری نمونه قبل و بعد از تهیه لام نیز اهمیت دارد. نمونهای که در دمای نامناسب یا برای مدت طولانی نگهداری شود، سلولهای آن تخریب میشوند و اطلاعات واقعی از وضعیت خون ارائه نمیشود. رعایت تمامی این نکات باعث میشود نتایج آزمایش دقیق و قابل اعتماد باشند و پزشک بتواند تشخیص درست بدهد.
نتیجهگیری
آزمایش لام خون محیطی یکی از دقیقترین روشهای بررسی سلامت سلولهای خونی است. این آزمایش اطلاعات ارزشمندی درباره وضعیت گلبولها و پلاکتها ارائه میدهد و به تشخیص بسیاری از بیماریها کمک میکند. با رعایت اصول تهیه و تفسیر صحیح لام، میتوان از بروز خطا جلوگیری کرد و نتیجهای قابل اطمینان به دست آورد.
سوالات متداول درباره آزمایش لام خون محیطی
خیر، فقط شامل گرفتن نمونه خون است و دردی جزئی دارد.
بین چند ساعت تا یک روز کاری آماده میشود.
بله، این آزمایش بیخطر است و در دوران بارداری نیز انجام میشود.
نتیجه باید همراه با سایر آزمایشها و نظر پزشک تفسیر شود.
